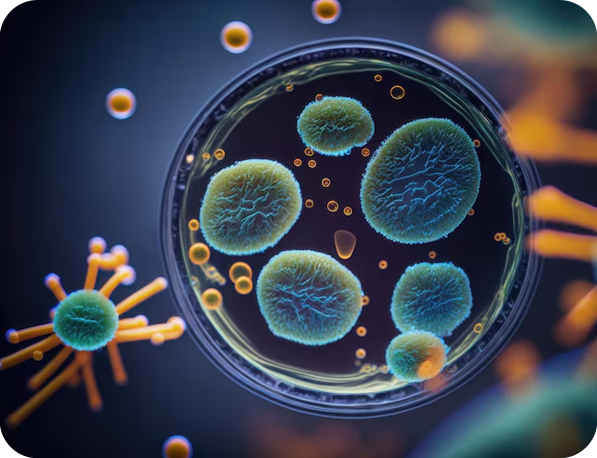

The origin of the
ATTACH Platform
The ATTACH Platform was born out of need over the last 5 years in Dr. Reuben’s laboratory at MD Anderson Cancer Center. ATTACHbio is advancing the ATTACH Platform dedicated to the rapid, unbiased, HLA- and antigen-agnostic isolation of antigen-specific T cells in human disease. Dr. Reuben’s lab was developing cell therapies for the treatment of lung cancer and facing significant hurdles associated with the cumbersome screening, identification and isolation process for antigen-specific T cells in solid tumors.
Since its inception, the platform has gone from a simple idea to a fully refined,versatile and sensitive method capable of enriching antigen-specific T cells in the context of cancer and other diseases.
“The ability to reliably and consistently identify T cell-antigen pairings is truly the single greatest hurdle facing the advancement of immunotherapy for the treatment of cancer and other diseases.”

Meet Our Team

Alexandre Reuben, Ph.D.
Founder, ATTACHbio
Assistant Professor, MD Anderson
Director, Immunology Program

Andy Bader, Ph.D.
Consultant, ATTACHbio
Entrepreneur-in-Residence, TMCi

Jason Bock, Ph.D.
Consultant, ATTACHbio
CEO, CTMC

Pamela Wenzel, Ph.D.
Consultant, ATTACHbio
Professor, UTH

John Heymach, M.D., Ph.D.
Consultant, ATTACHbio
Chair, Department of THNMO
Professor, MD Anderson

Technology
Find the Right T Cells. Treat the Disease.
How It Works
More about the ATTACH Platform
The ATTACH Platform (Assessment of T cells Tethered to Antigen Class I/II Histocompatibility) is based on microfluidics and separates antigen-specific from non-specific T cells based on the kinetics of their interactions with target cells. Because of its nature, ATTACH overcomes the roadblocks and biases of many other competing approaches and streamlines the process.
. Get In Touch
The ATTACH Advantage
Rapid
Identify target T cells in hours, not days.
Versatile
Works across antigens, tissues, and disease types.
HLA-agnostic
Validated across MHC restrictions in mice and humans.

No engineering
No need for engineered cell lines or reporters
Antigen-agnostic
Validated using unmutated antigens, single nucleotide variants, and indels in mice and humans.
Inexpensive
Streamlined workflow allows bypassing of antigen identification & eliminates associated costs.

Unbiased
No need for prior antigen identification or synthesis.
T cell recovery
Recovery of polyclonal T cells with wide range of affinities for improved function.
“The ATTACH platform has the potential to catapult the field forward by overcoming the hurdles typically associated with this process.”
Treatments We Cover
Applications

Oncology/Cell therapy
Antigen-specific T cell responses have been the focus of numerous cancer therapies across the spectrum. ATTACH allows the rapid identification and isolation of these T cells to better refine cell therapies for the treatment of cancer while depleting bystander T cells.
Get In Touch
Infectious diseases
Infectious diseases trigger antigen-specific T cell responses. ATTACH allows the rapid identification and isolation of these T cells for improved treatment.
Get In Touch
Autoimmunity
Autoimmunity is caused by the activation of self-reactive T cells. ATTACH allows the depletion of these T cells to mitigate autoimmune disease.
Get In Touch
Therapeutics
The identification of T cell receptors with therapeutic potential in cancer has remained a challenge fueled by lack of understanding of immunogenic tumor antigens. ATTACH allows the isolation of anti-tumor T cells and their receptors for the development of improved cell therapies.
Get In Touch
Biomarker development
Despite the acceptance of the importance of T cells in fighting human disease, the understanding of which specific clonotypes mediate therapeutic responses remains limited. ATTACH allows for identification of only patient-relevant clonotypes on a personalized basis, further refining the use of T cells as biomarkers of response and resistance to human disease.
Get In Touch
Other applications
Despite having been built to address the hurdles facing antigen-specific T cell identification, ATTACH’s versatility allows the isolation of virtually any interacting cells.
Get In Touch
attachbio Features
Why It Matters
The ability to reliably and consistently identify T cell-antigen pairings is truly the single greatest hurdle facing the advancement of immunotherapy for the treatment of cancer and other diseases.
The ATTACH platform has the potential to catapult the field forward by overcoming the hurdles typically associated with this process.
- Accelerates cancer TCR discovery
- Profiles autoimmune and infectious disease T cells
- Integrates seamlessly into discovery pipelines
- Scales from lab research to clinical development










